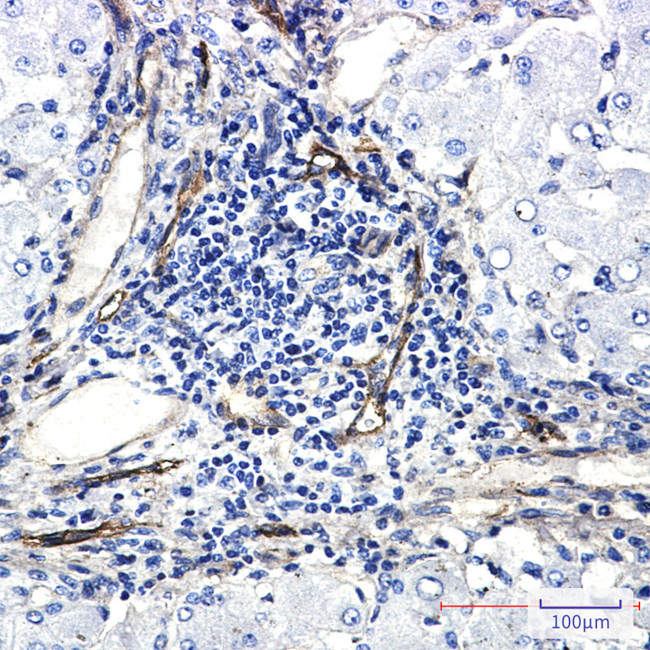
ORAI3 Antibody in Immunohistochemistry (Paraffin) (IHC (P))

Search
Invitrogen
ORAI3 Recombinant Rabbit Monoclonal Antibody (K01_2N72)
{{$productOrderCtrl.translations['antibody.pdp.commerceCard.promotion.promotions']}}
{{$productOrderCtrl.translations['antibody.pdp.commerceCard.promotion.viewpromo']}}
{{$productOrderCtrl.translations['antibody.pdp.commerceCard.promotion.promocode']}}: {{promo.promoCode}} {{promo.promoTitle}} {{promo.promoDescription}}. {{$productOrderCtrl.translations['antibody.pdp.commerceCard.promotion.learnmore']}}
图: 1 / 2
ORAI3 Antibody (MA564155) in IHC (P)


产品信息
MA564155
种属反应
宿主/亚型
Expression System
分类
类型
克隆号
抗原
偶联物
形式
浓度
规格
纯化类型
保存液
内含物
保存条件
运输条件
RRID
靶标信息
ORAI3 is a protein coding gene that is involved in calcium signaling and regulation of calcium homeostasis. It is a member of the ORAI family of proteins that form calcium release-activated calcium (CRAC) channels in the plasma membrane of cells. These channels are activated by depletion of calcium from the endoplasmic reticulum, leading to an influx of calcium ions into the cytoplasm. ORAI3 has been implicated in a variety of physiological processes, including T-cell activation, muscle contraction, and neurotransmitter release. Dysregulation of ORAI3 expression or function has been associated with various diseases, including immune disorders, cancer, and cardiovascular disease
仅用于科研。不用于诊断过程。未经明确授权不得转售。
篇参考文献 (0)
生物信息学
蛋白别名: Protein orai-3; Transmembrane protein 142C; unnamed protein product
基因别名: ORAI3; TMEM142C
UniProt ID: (Human) Q9BRQ5
Entrez Gene ID: (Human) 93129